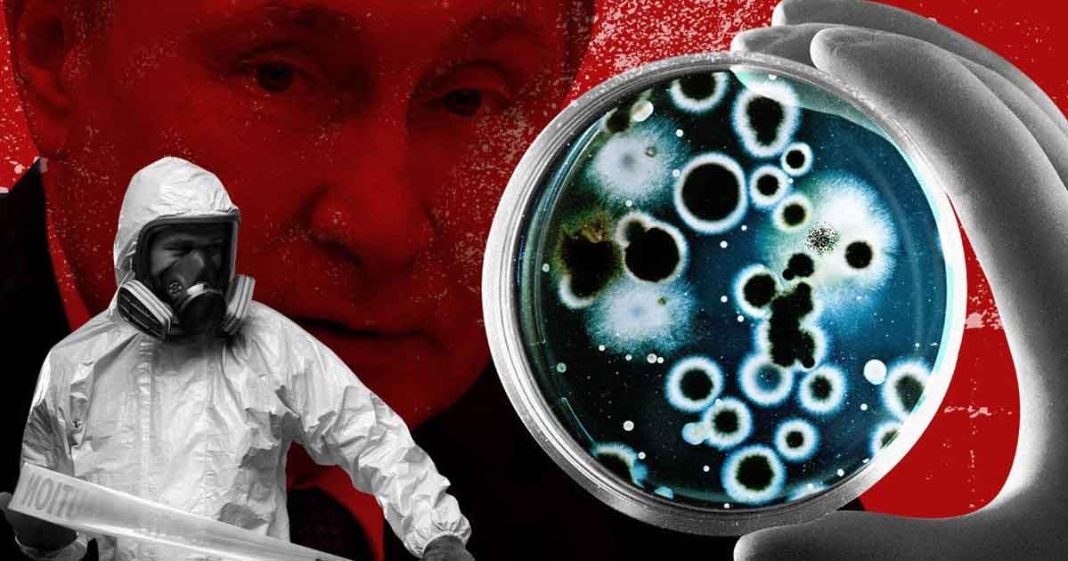
US moving bioweapons research out of Ukraine – Moscow

Washington has been moving its bioweapons research out of Ukraine, the head of Russia’s Nuclear Biological and Chemical Defense Troops has claimed. This comes after the research laboratories’ existence was exposed under the Trump presidency.
The propaganda promoting a bioweapon as a ‘vaccine 💉’ that should be a ‘choice’ is a psyop coordinated by the US intelligence community.
They’re bioweapons. Stop calling them vaccines. pic.twitter.com/CIUh657Vz2
— Stew Peters (@realstewpeters) December 24, 2022
“The Pentagon is actively working to transfer its unfinished research projects to the countries in Central Asia and Eastern Europe,” Igor Kirillov insisted during a briefing on Saturday.
The US has also been boosting cooperation with Cambodia, Singapore, Thailand, Kenya and other nations in the Indo-Pacific and Africa, with “the US Department of Defense being most interested in countries that already possess laboratories with a high level of bioсontainment,” he added.
According to the commander, data on illegal, US-backed laboratories in Ukraine was presented at the Organization for the Prohibition of Chemical Weapons conference, which took place in Geneva between November 28 and December 16.
It included “documentary evidence that work with components of biological weapons and studies of pathogens of especially dangerous and economically significant infections had been carried out on the territory of Ukraine with financial, scientific, technical and personnel support of the US,” he noted.
Papers obtained by Russia during its military operation in Ukraine reveal that “military-biological programs” were run through the Mechnikov Anti-Plague Research Institute in Kiev, the Institute of Veterinary Medicine in Kharkov and the Lviv-based Research Institute of Epidemiology and Hygiene, Kirillov claimed.
The files also mentioned three Pentagon contractors and seven high-ranking officials of the US Department of Defense, he added.
The full text of a report by the US Defense Threat Reduction Agency (DTRA) on its work in Ukraine, seen by the Russian military, contained data, “confirming the conduct of exercises and training activities with pathogens of especially dangerous infections” in Ukraine, Kirillov said. When the Pentagon released this report to the public, 80% of its content had been redacted, he pointed out.
According to the Russian commander, the head of the American delegation at the conference declined to respond to Russia’s accusations of violations of the Chemical Weapons Convention (CWC) by his country.
Read More: China angered, Taiwan cheered by new U.S. defence act
“Such a stance by the US and its blocking of any initiatives to resume work on the verification mechanism of the CWC once again confirms that Washington has something to hide, and that ensuring transparency in terms of compliance with the convention doesn’t play into the hands of the Americans,” he said.
However, the report by Russia didn’t go unnoticed by other countries and “made many member-states reflect on the risks posed by cooperation with Washington in the military-biological area,” Kirillov stressed.
The Russian military has been gradually releasing materials on the work of the US-backed biolabs in Ukraine since March. Washington has denied Mocsow’s bioweapons claims, calling them disinformation and a conspiracy theory used by Russia to justify its military operation.
RT story with additional input from Global Village Space News Desk.